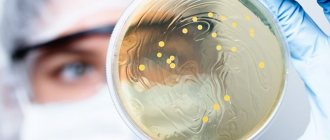

Щель между передними зубами в стоматологии называют диастемой. Данная аномалия весьма распространена и часто сопряжена с другим распространенным дефектом — тремами, зазорами разной величины в зубном ряду. Характерной чертой диастемы является наличие щели шириной 1-6 мм в пространстве между центральными резцами верхнего или нижнего зубного ряда. Однако в тяжелых клинических случаях ширина щели может достигать и 10 мм.
Чаще всего данный дефект наблюдается между резцами верхней челюсти, при этом диастема нижней челюсти считается редкостью. В зависимости от сложности аномалии становятся заметны некоторые изменения во внешности пациента, а также, дисфункции речи и дикции. Но поскольку многие люди не знают, что означает и как называется щель между зубами, некоторые из них мирятся с данным дефектом и избегают лечения, столь необходимого даже при такой, казалось бы незначительной проблеме.
Промежутки между зубами: почему возникают и как их вылечить
В настоящее время стоматологические клиники предоставляют широкий спектр услуг, позволяющих улучшить эстетику улыбки. При помощи современных технологий специалисты проводят качественное отбеливание, установку виниров, восстановление недостающих зубов путем протезирования. Для пациентов, обратившихся к специалисту с такими патологиями, как диастема или трема (их еще называют «щели между зубами»), также найдется несколько вариантов лечения. Из сегодняшней статьи вы сможете подробно узнать о том, чем отличаются и как исправить эти патологии.
Виды диастем
Прежде чем думать как исправить щель, следует выяснить, к какому именно виду относиться дистема — ложному или истинному.
Истинная
Аномалия истинного типа развивается в интактном зубном ряду, а также, характеризуется наличием широкого зазора между верхними резцами и мощной уздечкой губы, вплетенной в резцовый сосочек. При этом на рентгеновском снимке просматривается уплотненный шов небольшого размера. А оттягивание верхней губы влечет побеление слизистой оболочки резцового сосочка вплоть до его смещения. Такой вид щели между зубом и десной принято считать наследственным дефектом.
Ложная
Ложная диастема развивается в условиях отсутствия боковых резцов, различных аномалиях величины и формы центральных зубов, а также тогда, когда между передними резцами находится сверхкомплектный зуб ретенированного типа, который можно легко выявить рентгенологически. В данном случае уздечка верхней губы остается в норме, однако решение закрытия диастемы, как и в случае с истинной формой дефекта, принимается исходя из эстетических и речевых нарушений различной степени тяжести.
Что такое диастема
Иногда между центральными резцами человека образуется небольшой промежуток – от 1 до 6 миллиметров. Такое состояние получило название диастема зубов. Эта патология может располагаться как между верхними зубами, так и между нижними резцами человека. Встречается диастема не так уж и редко – примерно у 20% пациентов.
«Сколько себя помню, у меня всегда была щербинка на верхней челюсти. Никогда не комплексовала по этому поводу. Хотя мальчишки во дворе и пытались дразниться – зато свистела я громче, а они завидовали. Когда в институте обратилась к стоматологу, чтобы вылечить кариес, мне рассказали про диастему и посоветовали следить за здоровьем десен».
Карина П., отзыв с сайта baby.ru
Когда трема зубов — это нормально
Физиологические тремы относятся к особенности молочного прикуса во 2-м его периоде — в возрасте 6—7 лет.
Трема
возникает как следствие челюстного роста и за счёт трем происходит физиологическое смещение зубов в процессе их смены и устанавливается необходимое положение зубного ряда постоянного прикуса. То есть тремы между зубами являются частью жизненного цикла зубов человека.
Что такое трема
Трема между зубами тоже наблюдается у многих людей. Главное ее отличие от диастемы только в месте расположения. Трема также обозначает интервал между зубов, но находится в другом месте зубного ряда. Например, между латеральным резцом и клыком, клыком и премоляром и т.д. При нормальном строении величина этого расстояния у взрослого человека бывает до 0,7 мм. Если же промежуток составляет больше 1 мм, то врач поставит диагноз «трема».
Цены на лечение трем
Стоимость лечения тремы зубов зависит от характера патологии и выбранного направления – ортопедического или ортодонтического:
| Керамический винир на 1 зуб | От 15 000 рублей |
| Циркониевый винир на 1 зуб | От 20 000 рублей |
| Люминир на 1 зуб | От 40 000 рублей |
| Художественная реставрация зуба | От 3 500 рублей |
| Установка металлических брекетов | От 80 000 рублей |
| Установка керамических самолигирующих брекетов | От 110 000 рублей |
Тремы между зубами не появляются просто так: чаще всего они связаны с дефектами прикуса, которые нужно обязательно исправлять. В противном случае пациент столкнется с такими неприятными последствиями, как нарушение дикции, искажение черт лица, затруднение пережевывания пищи, склонность к развитию заболеваний пародонта, стирание зубной эмали, регулярное травмирование мягких тканей и даже нарушение работы желудочно-кишечного тракта.
Типы промежутков между зубами
Диастемы и тремы бывают нескольких видов. Некоторые диагностируют только у детей, но самые опасные из них возникают в старшем возрасте. Давайте более детально рассмотрим виды патологий:
- ложная диастема: появляется у детей в период прорезывания молочного ряда. Обычно закрытие такой диастемы проходит по мере появления молочных зубов или их смене на постоянные,
- истинная диастема: диагноз ставится, если после выпадения молочного ряда и появления всех коренных зубов между центральными резцами остается интервал более 1мм,
- физиологическая трема: возникает во время роста челюсти в детском возрасте. В ситуации, когда она развивается быстрее, чем успевают вырастать новые зубы. Это состояние проходит по мере появления всех элементов в ряду. Но родителям нужно наблюдать, чтобы ребенок не травмировал десны,
- патологическая трема: может быть провоцирована атрофией губчатой кости челюсти, отсутствием зубов в ряду. Например, из-за раннего удаления молочных зубов или неправильного развития зубных зачатков. Этот вид необходимо лечить.
Разновидности трем
Внимание! Зазоры между зубами, ширина которых составляет более 1 мм, считаются стоматологическим дефектом и требуют специальной коррекции. Существует две разновидности аномалии – физиологическая трема и патологическая трема.
Физиологические тремы появляются в детском возрасте. Происходит это в то время, когда у ребенка начинают выпадать молочные зубы, а на их месте вырастают постоянные. Причиной появления промежутков между зубами является рост костей челюсти. Челюсть увеличивается в размерах, а зубы расходятся в стороны. Обычно это становится заметно примерно к пяти годам. Если у ребенка в возрасте пяти лет все еще нет тремы между зубами, это может свидетельствовать о том, что челюстные кости развиваются с задержкой. В этом случае родители должны сводить ребенка к ортодонту на консультацию. Врач проведет осмотр и определит, все ли в порядке или же имеются какие-то отклонения. Появление трем у взрослых в возрасте 30–50 лет может указывать на развитие патологического процесса в тканях пародонта – убывания костной ткани, смещение.
Физиологические тремы появляются в детском возрасте. Причиной появления промежутков между зубами является рост костей челюсти. Это происходит во время выпадения молочных зубов и замены их на постоянные.
Патологические тремы могут развиться в период, когда постоянные зубы уже полностью сформировались. Причинами появления патологии становятся болезни десен, атрофия костной ткани и другие проблемы стоматологического характера. Зазоры между зубами могут быть единичными или множественными. Встречаются пациенты, у которых имеется много трем. При этом зубы выглядят довольно некрасиво. Обычно люди с таким дефектом стесняются своего внешнего вида и мечтают избавиться от щелей между зубами. К счастью, такая патология поддается коррекции.
Причины возникновения расстояний между зубами
Давайте более пристально изучим предпосылки возникновения рассматриваемых патологий. Причинами диастемы считают обычно следующие явления:
- физиологически неправильное развитие уздечки губы: укороченная уздечка прикреплена ниже верхней части резцов (верхняя челюсть), а на нижней челюсти уздечка может прикрепляться выше. Из-за этого боковые поверхности резцов не могут соприкоснуться, появляется дефект,
- генетическая предрасположенность: если у близкого родственника есть «щербинка», то высока вероятность проявления патологии и у потомков,
- вредные привычки: сосание пальца, неграмотное грудное вскармливание, применение сосок и пустышек не ортодонтической формы способно провоцировать появление промежутка между передними зубами.
Несмотря на то, что диастема – это, по сути, разновидность тремы, последняя может появиться в силу следующих причин (предыдущие, соответственно, также не исключаем):
- маленький размер зубов на фоне сильного развития челюсти: из-за этого в зубном ряду появляются щели,
- удаление или выпадение: если своевременно не установить протез или имплант, то возможно расползание элементов по ряду и, как следствие, появление промежутков,
- наследственный фактор: эта патология опять же может передаваться из поколения в поколение.
Интересный факт! Известно, что диастема – щербинка между передними резцами в 80% случаев передается от родителей к детям.
Причины образования диастемы
Существуют разные мнения по поводу образования большой щели между передними зубами. Некоторые исследователи полагают, что существенным фактором развития аномалии является низкий уровень прикрепления между центральными резцами короткой и мощной уздечки в районе верхней губы. Другие утверждают, что виной тому служит недостаточное обызвествление шва на небе. А третьи — отстаивают точку зрения касательно чрезмерной развитости верхней челюсти, что якобы приводит не только к появлению щели между передними зубами, но и к развитию щелей (трем) в целом.
Как бы то ни было, доказанной причиной развития нижнечелюстной диастемы можно считать высокое крепление уздечки языка, ограничивающее его движение и нарушающее дикцию.
При этом в качестве лечения применяется операция по отсечению уздечки и ушивание поверхности раны. Если же говорить о возникновении данной аномалии вообще, то интересной является тема передачи диастемы по наследству, озвученная еще в начале XX века, которая подразумевает наличие щели между передними зубами у порядка 50% родственников пациента.
Развитие диастемы верхних резцов обуславливается следующими причинами:
- присутствие зачатка сверхкомплектного зуба между корнями передних зубов;
- сопутствующая образованию диастемы уздечка верхней губы, прикрепленная слишком низко;
- микродентия центральных резцов;
- чрезмерно развитая костная перегородка в районе центральных резцов или челюсти в целом;
- ранняя потеря одного из передних молочных зубов;
- дефект формы и размеров, а также, полное отсутствие латеральных резцов;
- аномалия в положении всех зубов передней группы;
- запоздалая смена молочных зубов коренными.
Несмотря на обширный список причин, способных привести не только к появлению зазора между передними резцами, но и к образованию щелей самой распространенной причиной данной аномалии принято считать низкое прикрепление уздечки, исправляемое хирургическим путем.
Симптомы патологий и осложнения
После того, как мы ответили на вопросы про тремы и диастемы – что это такое и что они собой представляют, давайте рассмотрим признаки и последствия этих патологий. Понятно, что появление межзубных щелей уже само по себе обозначает симптом. Фактически, им все и ограничивается. Все остальное – это уже неприятные последствия, а порой и осложнения.
Итак, следует помнить, что десны и зубы при наличии таких промежутков подвержены многим заболеваниям:
- воспаление десенной ткани и связочного аппарата: проявляется в виде гингивита, пародонтита, пародонтоза,
- дефект речи: очень большие щели не всегда позволяет правильно ставить язык, это приводит к нарушению дикции,
- выпирание зубов вперед (к губам) или отклонение назад (к небу либо языку),
- травмы: возникают вследствие воздействия жесткой пищи,
- заболевания: кариес, пульпит могут быть спровоцированы травмой зубной эмали и дентина,
- стресс: зачастую у взрослых людей возникает психологический дискомфорт ввиду нарушения эстетики улыбки,
- рецессия десны и атрофия кости челюсти: в норме при пережевывании пищи нагрузка равномерно распространяется на весь зубной ряд. Если же в ряду есть промежуток, то ткани в этом месте становятся ослабленными.
Важно! Согласно исследованиям, более 60% обладателей щербинки между центральными резцами не думают о том, как убрать ее, и не собираются заниматься лечением диастемы. А пациенты с тремой в 90% случаев хотят исправить патологию.
Лечение межзубных щелей
Основными методами лечения тремы и диастемы являются:
- ортодонтическая терапия;
- применение виниров;
- коррекция щелей с использованием зубных коронок, имплантатов и других протезных приспособлений (ортопедическая стоматология);
- применение люминиров;
- френэктомия;
- борьба с болезнями пародонтита.
Ортодонтическое лечение определяет закрытие образовавшихся щелей с использованием брекет-систем. Важнейшей целью подобного метода является постепенное смещение зубов к зазору таким образом, чтобы между ними образовались равные промежутки.
Достоинства и недостатки ортопедического лечения
Основными достоинствами способа являются:
- постоянство достигнутого результата;
- отсутствие необходимости в замене средств коррекции щелей в дальнейшем;
- возможность получения достойного результата при отсутствии негативного воздействия на естественные зубы.
Недостатки лечения
Между тем, ортопедическое лечение зубных щелей имеет и несколько недостатков. К их числу относятся высокая продолжительность процедуры и ее дороговизна.
Коррекция винирами
Коррекция межзубных промежутков с использованием виниров является одним из наиболее дорогих, но в то же время эффективных методов лечения диастемы и тремы. Первоначально врач удаляет тонкий слой эмали под местной анестезией, делает слепок и покрывает обточенный зуб временным пластиковым виниром. Затем зубной техник производит по слепку керамический винир, передает его из зуботехнической лаборатории в стоматологический кабинет, а врач приклеивает его к поверхности зуба.
Основными достоинствами описанного метода являются:
- повышенная прочность керамических виниров;
- устойчивость применяемых приспособлений к окрашиванию;
- отсутствие необходимости в дополнительной полировке виниров.
Недостатки виниров
Отрицательной чертой подобной коррекции является неизбежное увеличение ширины естественных зубов, что не всегда благоприятно сказывается на эстетике улыбки пациента.
Коррекция коронками и имплантантами
Устранение диастемы и тремы с использованием коронок, имплантатов, зубных мостов и других протезных приспособлений производится в тех случаях, когда причиной образования межзубных щелей является недостаток зубов или аномалии их развития.
Недостатками указанного метода являются:
- наличие необходимости в проведении хирургического вмешательства;
- высокие требования к обработке твердых тканей здоровых зубов;
- неизбежное увеличение ширины зубов, оказывающее отрицательное влияние на общую эстетику улыбки.
Коррекция люминирами
Адгезивная стоматология подразумевает устранение диастемы и тремы с помощью тонких пластинок из композитных смол (люминиров).
Преимуществами этого способа являются:
- отсутствие выраженных временных затрат на проведение процедуры;
- низкая стоимость;
- отсутствие необходимости в удалении тканей здоровых зубов.
Недостатки люминиров
В свою очередь, недостатком использования люминиров является необходимость в периодическом проведении их шлифовки и коррекции.
Хирургическая коррекция – френэктомия
В тех случаях, когда причиной формирования межзубных щелей выступает слишком длинная уздечка, проводится ее укорачивание с применением хирургических методов (френэктомия). После операции диастема исчезает сама по себе или корректируется при помощи фигурных скобок.
Если возникновение межзубных промежутков было вызвано заболеваниями пародонта, то основным видом лечения является устранение патологического процесса, поражающего костные ткани. В дальнейшем проводится коррекция зубного ряда с использованием фигурных скобок.
Стоит отметить, что многие пациенты с диастемой или тремой чувствуют себя комфортно и не стремятся избавиться от данных патологий. Лечение требуется только в тех случаях, когда межзубные промежутки оказывают отрицательное влияние на внешность пациента, причиняют ему физический или психологический дискомфорт.
Диагностика заболеваний
Во время визита в стоматологию врач должен правильно установить диагноз, чтобы определить тяжесть случая, спланировать дальнейшие действия и подобрать способ коррекции. В некоторых случаях визуального осмотра недостаточно. Тогда ортодонт направит пациента на рентген или томографию. Здесь важно исключить или подтвердить наличие костной ткани в проблемном месте. Снимок также позволит увидеть расположение корней в челюсти, обнаружить недоразвитые зубные зачатки.
Как проводится лечение тремы элайнерами?
Ортодонтическое лечение трем производят в зависимости от ситуации, используя прозрачные каппы для исправления прикуса.
В течение такого лечения происходит сближение как видимых частей зубов, так и их корней с перестраиванием окружающих костных тканей.
Лечение трем на элайнерах дает гарантированный, стабильный результат
Самое интересное, что лечебный эффект при лечении тремы с помощью элайнеров Star Smile можно смоделировать и увидеть еще до начала лечения с помощью 3D визуализации на компьютере. Посмотрите, как происходит устранение проблем прикуса на компьютере — в жизни лечение проходит точно также, один-в-один:
Элайнеры обладают исключительной возможностью спрогнозировать все будущее лечение на компьютере и увидеть конечный результат еще ДО начала лечения.
Лечение: как избавиться от промежутков между зубами
Существуют хирургические и терапевтические методы исправления межзубных расщелин. Конечно, предпочтительнее использовать именно терапию – этим направлением занимается врач-ортодонт. Предварительно с пациентом обговаривается продолжительность достижения конечного результата, то есть нужно ли произвести удаление диастемы срочно или же за несколько месяцев. Немалую роль играет и цена терапии.
Рассмотрим все способы лечения:
- брекеты: так называют металлические, керамические или сапфировые аппараты, прикрепляемые к зубам на несколько месяцев с целью формирования правильного прикуса, то есть смещения положения зубов. Основной подход при лечении таких патологий, Стоимость начинается от 25 тысяч рублей. Подойдет для лечения многочисленных трем по ряду,
- каппы или силиконовые элайнеры: альтернативы брекетам. Также подойдут при наличии множественных трем. Цена – от 180 тысяч рублей за комплекс,
- пломба или закрытие композитным материалом: щель между фронтальными резцами корректируется пломбирующим материалом способом художественной реставрации диастемы. Цена начинается от 4000 рублей за один зуб. Этот и нижеописанные методы не используют при треме, поскольку речь идет только о восстановлении эстетики фронтальной области,
- виниры при диастеме: керамические накладки толщиной 0,5-0,7 мм. Эти микропротезы используются десятилетиями и по праву держат пальму первенства по качеству восстанавливаемой эстетики улыбки. Однако, для их установки нужно стачивать собственную эмаль, что подойдет не каждому пациенту. Служат виниры 10-15 лет. Цена 1 элемента начинается от 15 тысяч рублей,
- люминиры (это также пластинки, но более тонкие – толщиной около 0,2 мм). Их плюсы в быстрой и почти безболезненной установке, без стачивания эмали. Стоимость – от 30 тысяч рублей за 1 пластинку. Но такая реставрация подходит только к идеальным зубам. Коррекция этим способом не используется, если ширина диастемы больше 7 мм,
- карбоновые фиксаторы: применяют у детей для стягивания фронтальных резцов. Устанавливаются на срок от 12 месяцев.
Что касается установки брекетов и элайнеров – это к ортодонту. К нему нужно обязательно обратиться, если у ребенка имеются щели по ряду вне зависимости от прикуса – молочный он или постоянный. Важно начать лечение как можно раньше, чтобы во взрослом возрасте не было проблем.
По коронкам, винирам или люминирам нужно обращаться к стоматологу-ортопеду (его еще называют протезистом). Эти методики оправданы в тех ситуациях, когда кроме щелей никакие другие патологии прикуса не присутствуют. И, соответственно, нет осложнений.
«В прошлом году решила сделать пломбу на месте щербинки. Мне не нравилось, как выглядит моя улыбка, хотя родители и парень утверждали, что она придает мне шарм. Что сказать – процедура оказалась не очень долгой, чуть больше часа. Первое время пломба мне мешала, хотелось вытолкнуть ее языком. Но через пару недель я перестала ощущать дискомфорт. Зато теперь отражение в зеркале мне очень нравится!»
Оксана И., отзыв с сайта irecommend.ru
Хирургические методы лечения патологии включают в себя следующие (проводятся они только при наличии действительно сложных патологий):
- кортикостомию: коррекция небного шва, требуется, если шов между центральными резцами заполнен соединительной и костной тканью. Проводится под анестезией. Неприятная процедура, особенно для детей. Длительная реабилитация,
- удаление молочных резцов: если их размер очень большой. Постоянные резцы вырастают нормального размера.
Косметические способы лечения
Современная стоматология предлагает пациентам ряд быстрых косметических решений по устранению дефекта — виниры и наращивание зуба:
- Виниры представляют собой тонкие накладки на зубы, выполненные из фарфора или композитного материала. Для их надежного крепления используется специальный состав, по функциям напоминающий суперклей, наносимый на предварительно обработанную поверхность зуба. В целом, они быстры в реализации и удобны в качестве временного решения, но не исправляют аномалию физически.
- В случае с наращиванием, фактического лечения диастемы тоже не происходит, однако данный способ заделать щель между зубами является наиболее предпочтительным, если речь идет только о реставрации. Он подразумевает нанесение на стенки передних зубов некоторого количества слоев фотоматериала, призванного заполнить собой существующую щель. И хотя надежность наращивания выше, чем например при использовании виниров, прочность созданного покрытия несравнима с естественной стойкостью зубов.
Симптомы появления диастемы
Дефект передних резцов заметен с первого взгляда. Его ширина может колебаться от нескольких миллиметров до сантиметра. Основная проблема для пациента — это косметический дефект, хотя многие не комплексуют из-за щели между зубами. Если эта аномалия не является причиной других проблем и не вызывает недовольства у пациента, можно не предпринимать никаких действий.
Часто диастема сочетается с неправильным прикусом и нарушениями речи. Такие пациенты обязательно нуждаются в стоматологической помощи. Аномальное положение резцов является располагающим фактором в развитии пародонтита.
Нарушение, сопровождающееся поворотом резцов вокруг своей оси, обычно является серьезным внешним дефектом и вызывает трудности при откусывании пищи.
Поставить диагноз диастема несложно. Проблема заметна при осмотре ротовой полости. Специалисту необходимо оценить степень нарушения, выявить наличие сопутствующей патологии и установить причину нарушения.
Для уточнения диагноза стоматолог может назначить такие дополнительные методы исследования, как рентгенография, снятие слепков. Эти мероприятия позволяют уточнить степень расхождения зубов, оценить угол из наклона, получить информацию о состоянии корней и альвеолярного отростка челюсти, выявить нарушения прикуса и другие аномалии положения зубов.
Комплексная диагностика позволяет подобрать оптимальную тактику лечения, позволяющую полностью устранить дефект.
Диастема у знаменитостей
Зубы — визитная карточка любого известного человека, и, по мнению многих, они должны быть идеальными. Но есть немало звезд, которые щербинку между зубами превратили в свою изюминку. Если верить физиогномике, то щели между зубами — это признак таланта и творческого потенциала.
Знаменитые женщины с диастемой
К списку звезд с диастемой, прославившихся в прошлом столетии, помимо Бриджит Бардо и Орнеллы Мути можно добавить Лорен Хаттон, покорившую фэшн-индустрию еще в 60-х годах XX века. Среди современных моделей — это Джорджия Мэй Джаггер, ставшая лицом рекламной компании Chanel.
Французских знаменитостей диастема делает еще более привлекательными и является неотъемлемой частью их имиджа. Кроме Ванессы Паради с ее ярко выраженной диастемой можно вспомнить актрису Джейн Биркин, считавшую щербинку «забавной мелочью». Не спешит избавляться от этого дефекта и Леа Сейду — исполнительница роли Belle из «Красавицы и Чудовища».
Американки в этом плане более консервативны и стремятся к голливудской улыбке. Звезда фильма «50 оттенков серого» Дакота Джонсон когда-то относилась к своей диастеме с большим чувством юмора. Чтобы в этом убедиться, достаточно посмотреть видеоролик известной американской телепередачи с ее участием. Но со временем актриса избавилась от своей диастемы.
Знаменитые мужчины с диастемой
Диастемы и тремы у известных мужчин — явление довольно частое. Среди ветеранов Голливуда, избавившихся от промежутка между зубами, отметим Арнольда Шварценеггера, Тома Круза, Николаса Кейджа. А вот известный режиссер Оливер Стоун не стал лечить диастему. Щербинка не мешает широко улыбаться и Вуди Харрельсону, Эдди Мерфи, Лоуренсу Фишберну.
Среди представителей молодого поколения, которые исправили диастему в юности, выделим Зака Эфрона и Мэттью Льюиса.
Свою «любовь» к щербинкам своеобразно выразили Джонни Депп и культовый режиссер Тим Бертон, создав образ Безумного Шляпника в фильме «Алиса в Стране чудес».
Можно по-разному относиться к диастеме и тремам, но отрицать, что кому-то из звезд они действительно к лицу, не стоит. Диастема может подчеркнуть яркую внешность и сделать ее запоминающейся.
С чем связано появление аномалии?
Тремы могут появляться по разным причинам. Это наследственность или внешние факторы. Давайте рассмотрим самые распространенные причины.
- Генетическая предрасположенность. Если у одного из родителей увеличены зазоры между зубами, то велика вероятность того, что ребенок унаследует эту особенность.
- Врожденная патология уздечки верхней губы у ребенка. Если пленка прикреплена очень низко и располагается в непосредственной близости от зубов, то за счет ее чрезмерного натяжения могут образоваться увеличенные зазоры.
- Также патология может появиться при врожденном мелком размере зубов или усиленном росте челюстных костей.
- В детском возрасте тремы могут образоваться, если малыш длительное время не расстается с соской, имеет привычку тащить в рот собственные пальцы или какие-либо предметы.
- Дефект может развиться во время смены временного прикуса на постоянный прикус. Во взрослом возрасте пространство увеличивается из-за потери единичного зуба вследствие образования свободного промежутка.
Независимо от причин появления трем не нужно мириться с этим дефектом. В современной стоматологии существуют эффективные способы коррекции. Исключение составляют ситуации, когда щели между зубами образуются у ребенка во время смены молочных зубов на постоянные. В этом случае размеры зазоров могут нормализоваться самостоятельно.
Причины
Среди причин, вызывающих появление щелей, выделяют наследственные и приобретённые. К наследственным относят:
- подобные аномалии у кого-нибудь из родителей – это повышает риск диастемы или тремы у ребёнка;
- аномальный размер или тип прикрепления уздечки губы;
- увеличенный размер челюсти;
- маленькие размеры зубных коронок;
- несвоевременная смена зубов;
- аномалии зубных зачатков.
Среди причин, которые вызывают появление щелей на протяжении жизни, выделяют:
- длительное использование пустышки;
- искусственное вскармливание;
- детские вредные привычки – закусывание губы, сосание пальцев и прочих предметов;
- потеря зубов без последующего протезирования, из-за чего соседние элементы немного смещаются вбок;
- хронические воспалительные болезни дёсен;
- частичная атрофия челюстной кости.
Иногда промежуток может возникнуть во время лечения прикуса брекетами. Это вариант нормы, врач корректирует силу и направление давления, поэтому к концу коррекции прикус становится нормальным.
Дакота Джонсон откорректировала прикус и убрала диастему
Отказ от лечения
Решение о коррекции прикуса, направленного на избавление от щели, принимает пациент. Следует знать, что такое нарушение несёт определённые опасности как для стоматологического здоровья, так и для других систем. В щели постоянно забивается пища, которая остаётся там некоторое время. Это многократно увеличивает риск появления кариеса. Распределение нагрузки на режущий край происходит неравномерно, что становится причиной истирания эмали или пародонтита, возможно оголение корней. Щель со временем почти в каждом случае увеличивается, кроме того, заметно усиливается подвижность зубов.
Шер Ллойд, популярная участница английского релиза культового шоу X Factor после коррекции прикуса
Кроме того, данное нарушение провоцирует ухудшение работы ЖКТ, поскольку пережёвывание пищи производится не так качественно, как это необходимо.
Большой промежуток способствует попаданию на слизистую оболочку твёрдой пищи, что приводит к хронической травматизации дёсен. Это вызывает воспаления десневой ткани, гингивит.
Ещё одно осложнение – нарушение работы височно-нижнечелюстного сустава, которое сопровождается болью во время пережёвывания пищи или при разговоре.
Разновидности диастем
Зазоры между зубами объединяют в группы в зависимости от наличия определенных признаков. В первую очередь разделяют диастемы на:
- истинную, которая сохраняется у человека после смены зубов и окончании формирования постоянного прикуса;
- ложную, которая появляется на разных этапах развития зубочелюстной системы и закрывается самостоятельно по мере прорезывания всех постоянных зубов на челюсти.
По форме диастема может быть:
- симметричная, если резцы находятся на одинаковом расстоянии друг от друга;
- асимметричная, если отклоняется в сторону только один зуб или один из пары наклонен больше, чем другой.
Устранение зубных зазоров
Тремы не всегда доставляют неудобства, но следует учесть, что они имеют тенденцию к расширению, поэтому лучше своевременно принять меры. В современной стоматологии существует немало способов решения этой проблемы. На осмотре врач оценивает состояние зубов, выраженность зазора, учитывает индивидуальные особенности пациента и после этого принимает решение об использовании одного из ортодонтических аппаратов. Это могут быть брекеты, капы или ортодонтические пластины.
Когда ортодонтическое лечение не требуется, можно пойти более простым путем, обратившись в стоматологическую клинику для изготовления и установки виниров. Искусственные накладки из композитных материалов или фарфора закроют щель и полностью устранят косметический дефект.
Из этой статьи вы узнали про распространенный дефект зубного ряда. В завершение предлагаем вам посмотреть полезное видео, в котором стоматолог расскажет вам, почему лучше убирать щели между зубами.
В чём разница
Трема и диастема – это два близких понятия. Тремой называют щель между соседними зубами с размером от 1 мм. Появляются такие недостатки как на верхней, так и на нижней челюсти. Они могут располагаться в одном месте, но бывают случаи множественных трем.
Диастемой называют щель между фронтальными зубами – молярами. Как правило, именно она доставляет человеку самый большой дискомфорт, поскольку при размере выше 1,5 мм она очень заметна для окружающих.
Способы устранения
Многие люди длительное время живут с данной аномалией, не обращаются в клинику и чувствую себя достаточно комфортно.
Но, когда с течением времени трема увеличивается в размерах, врачебная помощь становится необходимостью. Существует несколько вариантов решения проблемы.
Ортодонтические конструкции
Считается одним из самых долговременных, зато самых надежных и эффективных вариантов зубной реставрации и устранения щелей. Метод щадящий, не слишком травмирует зубную эмаль, так как не предполагает дополнительное стачивание части органа.
В детском возрасте ставят ортопедические пластины, а уже чуть позже, примерно с 14 лет можно порекомендовать ношение брекет-конструкций, среди которых есть абсолютно современные, практически невидимые постороннему глазу, аппараты.
Результативность способа определяется степенью выраженности патологии и возрастом пациента. У ребенка ортодонтические конструкции практически в 100% показывают положительную динамику.
Принцип закрытия диастем и трем между зубов с помощью брекет систем смотрите в видеоматериале.
Имплантация
Вариант будет результативным, если природа патологии кроется в частичной адентии. В этой ситуации пустоты, появившиеся вследствие удаления одного или нескольких органов, заполняют искусственными копиями – имплантатами.
У этого метода есть один существенный недостаток – его использование целесообразно только при незначительно выраженных отверстиях, близких к состоянию нормы.
Если процессы расхождения зубов запущены, от имплантации лучше отказаться в пользу другого варианта.
Виниры и люминиры
Практически идеальное решение при любой степени патологии. По эстетичности превосходят все описанные методы.
Принцип лечения заключается в следующем – искусственные накладки надежно прикрывают межзубные отверстия, добиваясь целостности челюстного ряда.
Крепятся они на стоматологический клей, который наносится на живые органы. Виниры имеют различные размеры, что позволяет подобрать оптимальный вариант.
Предлагаем посмотреть фото брекетов In Ovation и узнать, какие дефекты можно устранить с их помощью. В этой статье все самое важное об имплантах из Южной Кореи Имплантиум.
По этому адресу https://dr-zubov.ru/krasota-i-uxod/professionalnaya-chistka/air-flow-otzyvy-ob-effektivnosti-metoda-sovremennosti.html смотрите видео чистки зубов Air Flow.
Композитные материалы
Надежный метод, при котором поверхность органа искусственно наращивается до необходимого размера и формы, за счет чего устраняются тремы. Способ не травмирует эмаль, поскольку поверхность не стачивается и не шлифуется.
Ограничением к применению может стать аллергическая непереносимость, которая встречается довольно редко.
Современные композитные материалы – это качественные, эластичные компоненты, которые позволяют проводить процедуру многократно.
Эффективность несколько ниже, чем у других вариантов, зато установка и лечение проходит быстрее и деликатнее.
При обращении к профильному специалисту и детально проведенной диагностике доктор подберет оптимальный вариант с учетом клинической картины аномалии.
В данном случае только мнение стоматолога является авторитетным, иначе результат от лечения может быть практически нулевым.